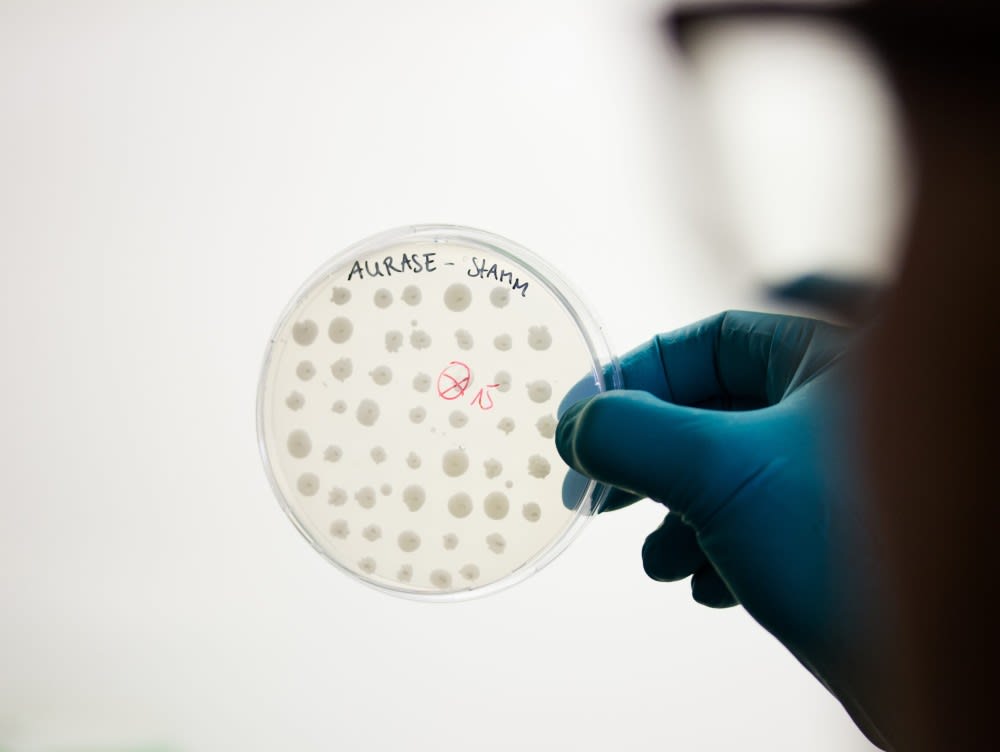
SolasCure announces Series A raise

Posted 11th June 2024
Posted 2 years ago
By GS Verde Group
Athena Security Solutions Completes Employee Ownership Transition with GS Verde Group's Expert Guidance
Athena Security Solutions, a London-based elite security company, has successfully completed an Employee Ownership Trust (EOT) in a deal advised on GS Verde Group.